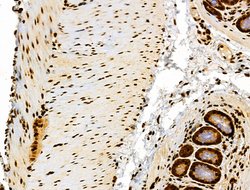
Invitrogen Phospho-RSK Pan (Ser221, Ser227, Ser218, Ser232) Polyclonal

missing translation for 'onlineSavingsMsg'
Learn More
Learn More
Invitrogen™ Phospho-RSK Pan (Ser221, Ser227, Ser218, Ser232) Polyclonal Antibody


Rabbit Polyclonal Antibody
Brand: Invitrogen™ PA5114637
This item is not returnable.
View return policy
Description
Antibody detects endogenous levels of RSK1/2/3/4 only when phosphorylated at Ser221/227/s218/232.
The p90 ribosomal S6 kinases (RSKs) comprise a family of serine/threonine kinases that lie at the terminus of the ERK pathway. In humans, the RSK family consists of four isoforms (RSK1 to-4). RSK family members are unusual among serine/threonine kinases in that they contain two distinct kinase domains, both of which are catalytically functional. Theses kinase domains are activated in a sequential manner by a series of phosphorylations. RSK regulates gene expression via association and phosphorylation of transcriptional regulators including c-Fos, estrogen receptor, NFkappaB/IkappaB alpha, cAMP-response element-binding protein (CREB). ERK activates the C-terminal kinase of RSK, leading to activation of the N-terminal kinase. Members of the RSK family are present in the cytoplasm as well as the nucleus. Addition of growth factor to the cells results in the activation of both cytosolic and nuclear RSK and the translocation of the cytosolic RSK into the nucleus upon activation. The activation and nuclear translocation of RSK result in phosphorylation and activation of transcription factors.
Specifications
| Phospho-RSK Pan (Ser221, Ser227, Ser218, Ser232) | |
| Polyclonal | |
| Unconjugated | |
| RPS6KA1 | |
| 1110069D02Rik; 2610524K04Rik; 90 kDa ribosomal protein S6 kinase 1; 90 kDa ribosomal protein S6 kinase 2; 90 kDa ribosomal protein S6 kinase 3; 90 kDa ribosomal protein S6 kinase 4; 90 kDa ribosomal protein S6 kinase 6; 90kDa; AI848992; C130006E23; CLS; D17Wsu134e; dJ590P13.1 (ribosomal protein S6 kinase, 90kD, polypeptide 1); HU-1; HU-2; HU-3; Insulin-stimulated protein kinase 1; ISPK1; ISPK-1; MAP kinase-activated protein kinase 1a; MAP kinase-activated protein kinase 1b; MAP kinase-activated protein kinase 1c; MAPK-activated protein kinase 1a; MAPK-activated protein kinase 1b; MAPK-activated protein kinase 1c; MAPKAP kinase 1a; MAPKAP kinase 1b; MAPKAP kinase 1c; MAPKAPK1A; MAPKAPK-1a; MAPKAPK1B; MAPKAPK-1b; MAPKAPK1C; MAPKAPK-1c; MAPKAPK1D; mitogen- and stress-activated protein kinase 2; mitogen- and stress-activated protein kinase-2; mitogen-activated protein kinase-activated protein kinase 1C; mMSK2; MPK-9; MRX19; Msk2; Nuclear mitogen- and stress-activated protein kinase 2; p90 rsk; p90rsk; p90-RSK 1; p90-RSK 2; p90-RSK 3; p90-RSK 6; p90RSK1; p90-Rsk1; p90RSK2; p90-RSK2; p90RSK3; p90-RSK3; p90RSK6; p90S6K; pp90rsk; pp90RSK2; pp90RSK3; PP90RSK4; Protein-tyrosine kinase Mpk-9; ribosomal protein kinase B; ribosomal protein S6 kinase 2; ribosomal protein S6 kinase A1; ribosomal protein S6 kinase A2; ribosomal protein S6 kinase A3; ribosomal protein S6 kinase A4; ribosomal protein S6 kinase A6; ribosomal protein S6 kinase alpha 1; ribosomal protein S6 kinase alpha 2; ribosomal protein S6 kinase alpha 4; ribosomal protein S6 kinase alpha-1; Ribosomal protein S6 kinase alpha-2; ribosomal protein S6 kinase alpha-3; Ribosomal protein S6 kinase alpha-4; ribosomal protein S6 kinase alpha-6; ribosomal protein S6 kinase polypeptide 1; ribosomal protein S6 kinase polypeptide 3; ribosomal protein S6 kinase polypeptide 6; ribosomal protein S6 kinase, 90kD, polypeptide 1; Ribosomal protein S6 kinase, 90kD, 1; ribosomal protein S6 kinase, 90kD, polypeptide 2; ribosomal protein S6 kinase, 90kD, polypeptide 4; ribosomal protein S6 kinase, 90kDa, polypeptide 1; ribosomal protein S6 kinase, 90kDa, polypeptide 2; ribosomal protein S6 kinase, 90kDa, polypeptide 3; ribosomal protein S6 kinase, 90kDa, polypeptide 4; ribosomal protein S6 kinase, 90kDa, polypeptide 6; ribosomal protein S6 kinase, polypeptide 2; ribosomal protein S6 kinase, polypeptide 4; ribosomal S6 kinase 1; Ribosomal S6 kinase 2; ribosomal S6 kinase 3; Ribosomal S6 kinase 4; RLSK; RP11-393H10.3; Rps6ka1; RPS6KA2; Rps6ka3; RPS6KA4; RPS6KA6; Rps6ka-rs1; RSK; Rsk1; RSK-1; Rsk2; RSK-2; Rsk3; RSK-3; RSK4; RSK-4; RSKB; RSK-B; RSK-like protein kinase; S6K-alpha; S6K-alpha 1; S6K-alpha 2; S6K-alpha 6; S6K-alpha-1; S6K-alpha2; S6K-alpha-2; S6K-alpha3; S6K-alpha-3; S6K-alpha-4; S6K-alpha-6 | |
| Rabbit | |
| Sequential Chromatography | |
| RUO | |
| 110651, 117269, 20111, 20112, 27330, 317203, 361715, 501560, 56613, 6195, 6196, 6197, 67071, 81771, 8986 | |
| -20°C | |
| Liquid |
| Immunohistochemistry (Paraffin), Western Blot | |
| 1 mg/mL | |
| PBS with 50% glycerol and 0.02% sodium azide | |
| O75676, P18653, P18654, P51812, Q15349, Q15418, Q63531, Q7TPS0, Q9UK32, Q9WUT3, Q9Z2B9 | |
| RPS6KA1, RPS6KA2, Rps6ka3, RPS6KA4, RPS6KA6 | |
| A synthesized peptide derived from human RSK1/2/3/4 around the phosphorylation site of Ser221/227/s218/232. | |
| 100 μL | |
| Primary | |
| Human, Mouse, Rat, Monkey | |
| Antibody | |
| IgG |
Product Content Correction
Your input is important to us. Please complete this form to provide feedback related to the content on this product.
Product Title
Spot an opportunity for improvement?Share a Content Correction